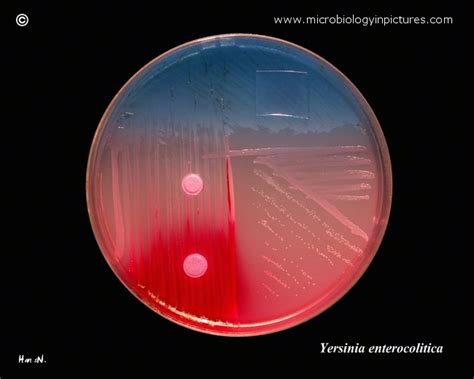
yersinia enterocolitica  endo   biochemical slope positive

Jika kamu sedang mencari Yersinia Enterocolitica, maka anda berada di halaman yang tepat. Kami menyediakan aneka Yersinia Enterocolitica yang bisa anda pesan online. Silakan hubungi kami via +6282245078486, jangan lupa sertakan juka gambar yang diinginkan.
Kami mengirim paket Yersinia Enterocolitica melalui berbagai ekspedisi, misalnya JNE, JNT, POS, dll. Kami juga menerima pembayaran via BCA/Mandiri/dll. Pengiriman biasanya tidak sampai seminggu sudah sampai dan kami sertakan pula nomor resi yang bisa digunakan untuk tracking barang secara online.

Tidak hanya Yersinia Enterocolitica, anda juga bisa melihat gambar lain seperti
Under Microscope,
XLD Agar,
Food Poisoning,
Gram-negative,
Identification Chart,
Ferment Lactose,
SS Agar,
Bacterial Morphology,
TCBS Agar,
Que ES,
and Scale Bar.
Berbagai Contoh Yersinia Enterocolitica
Berikut kami sertakan berbagai contoh gambar untuk Yersinia Enterocolitica, silakan save gambar di bawah dengan klik tombol pesan, anda akan kami arahkan pemesanan via WA ke +6282245078486.
 550×369
550×369
yersinia pathogenicity infection transmission britannica
Order Sekarang
 750×586
750×586
yersinia enterocolitica alchetron social encyclopedia
Order Sekarang
 900×1200
900×1200
yersinia enterocolitica yersinia pseudotuberculosis clinical tree
Order Sekarang
 650×520
650×520
yersinia enterocolitica endo biochemical slope positive
Order Sekarang
 1600×1157
1600×1157
yersinia enterocolitica bacteria stock illustration illustration
Order Sekarang
 1600×1157
1600×1157
yersinia enterocolitica bacteria stock illustration cartoondealercom
Order Sekarang
 850×543
850×543
yersinia enterocolitica food poisoning yersiniosis
Order Sekarang
 800×599
800×599
yersinia enterocolitica bacteria stock image science
Order Sekarang
 800×533
800×533
yersinia enterocolitica bacteria illustration stock image
Order Sekarang
 641×800
641×800
yersinia enterocolitica bacterium sem stock image
Order Sekarang
 1500×1000
1500×1000
yersinia enterocolitica infection symptoms diagnosis treatment
Order Sekarang
 1890×1435
1890×1435
yersinia enterocolitica invasion sicily yersiniosis zealand
Order Sekarang
1300×956
1300×956
yersinia enterocolitica bacteria illustration stock photo alamy
Order Sekarang
 900×673
900×673
yersinia enterocolitica bacteria photograph scimat pixels
Order Sekarang
 835×1081
835×1081
yersinia sppyersiniosis concise medical knowledge
Order Sekarang
 900×673
900×673
yersinia enterocolitica bacteria photograph scimat fine art america
Order Sekarang
 900×600
900×600
yersinia enterocolitica bacteria photograph kateryna kon fine art
Order Sekarang
 1600×1157
1600×1157
yersinia enterocolitica bacteria illustration stock illustration
Order Sekarang
Temukan solusi terbaik untuk kenyamanan ruang Anda dengan Yersinia Enterocolitica! Produk peredam suara dan panas ini menawarkan performa maksimal dengan harga yang terjangkau. Dapatkan kualitas unggul tanpa menguras kantong, dan nikmati suasana tenang serta sejuk di setiap sudut rumah atau kantor Anda. Pilih Yersinia Enterocolitica – pilihan cerdas untuk investasi jangka panjang!









